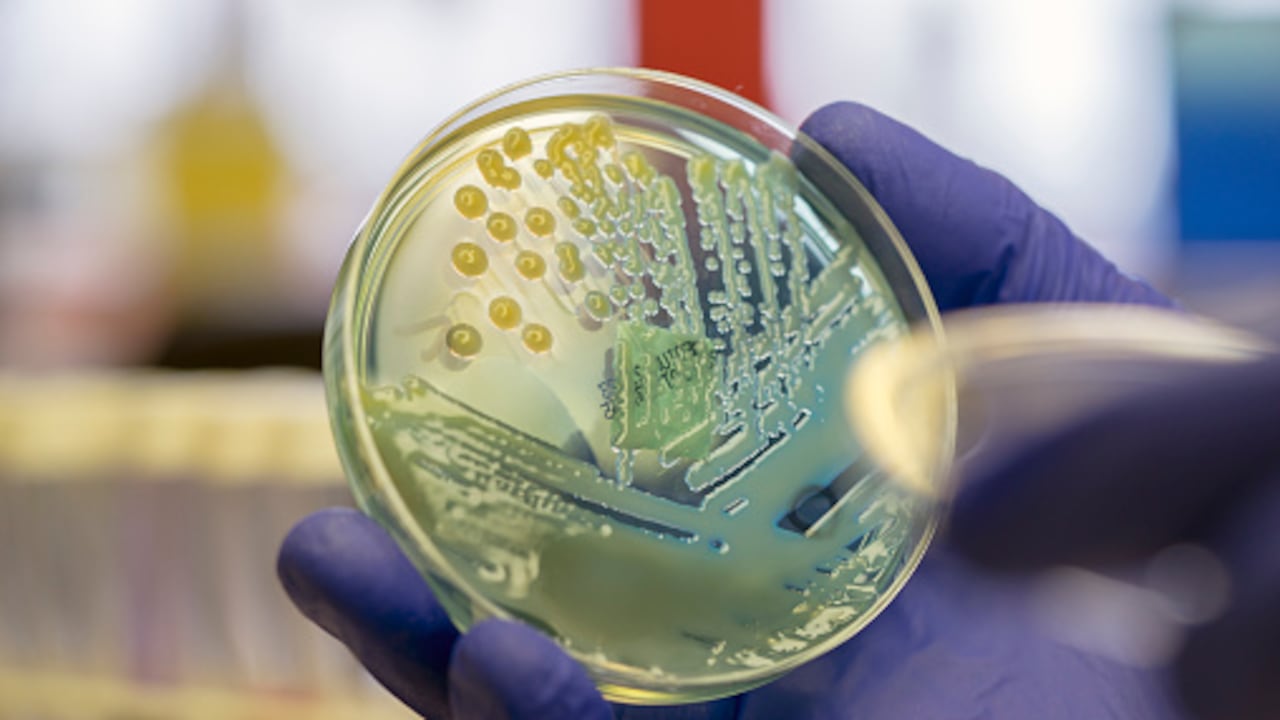
Se trata de un fenómeno en el que bacterias, virus, hongos y parásitos desarrollan la capacidad de resistir medicamentos previamente efectivos.

El Instituto Nacional de Vigilancia de Medicamentos y Alimentos, Invima, hizo un llamado a la población este lunes para que realice un uso responsable de los antibióticos, ante la creciente amenaza de la resistencia antimicrobiana (RAM) que se presenta en el mundo. El llamado se hace en el marco de la Semana Mundial de la Concientización sobre la Resistencia a los Antimicrobianos, que se desarrolla del 18 al 24 de noviembre.
Se trata de un fenómeno en el que bacterias, virus, hongos y parásitos desarrollan la capacidad de resistir medicamentos previamente efectivos, lo que se ha convertido en un grave desafío para la salud pública del planeta.

Se sabe que la resistencia antimicrobiana dificulta el tratamiento de infecciones, además de que prolonga la duración de enfermedades, aumenta las tasas de mortalidad y eleva los costos de atención médica en las personas.
Por ello, a juicio de los expertos, resulta crucial que todos los actores clave en salud y la ciudadanía en general, comprendan la importancia de usar antibióticos únicamente cuando sean necesarios y bajo supervisión médica.
“La resistencia antimicrobiana representa un desafío crítico para la salud pública global. Es esencial que tanto los profesionales de la salud como la ciudadanía entiendan la importancia de utilizar los antibióticos de manera responsable y solo bajo supervisión de un profesional”, señala Francisco Rossi, director general del Invima.

La entidad explica además que la farmacovigilancia, que tradicionalmente se centraba en la detección de reacciones adversas a medicamentos, ha ampliado su enfoque para incluir el monitoreo de la efectividad de los tratamientos y detectar patrones de uso inapropiado.
A través de dicha vigilancia, el Invima identifica señales de resistencia que permiten una investigación más profunda y respaldan los programas de administración de antimicrobianos (AMS).
La directora de Medicamentos y Productos Biológicos, Sandra Montoya, asegura que “la farmacovigilancia juega un papel crucial en la identificación de señales de resistencia antimicrobiana. A través de un monitoreo constante, podemos ajustar las políticas de tratamiento y garantizar la seguridad de los pacientes, previniendo así la propagación de patógenos resistentes”.

En ese sentido, algunas recomendaciones importantes para el uso responsable de antimicrobianos, son:
- Evitar la automedicación: La automedicación con antimicrobianos es peligrosa y contribuye directamente a la resistencia. Por ello, es fundamental que estos medicamentos solo se usen bajo estricta prescripción médica.
- Completar el tratamiento: Interrumpir el tratamiento antes de finalizarlo, ocasiona que algunos microorganismos sobrevivan y se vuelvan resistentes. Es indispensable completar el tratamiento, según lo indicado.
- No compartir medicamentos: Cada tratamiento es específico para una persona; compartir antimicrobianos puede agravar el problema de la resistencia antimicrobiana y ese se ha convertido en un error frecuente en miles de personas.

El Invima hace un llamado a los profesionales de la salud, para seguir los protocolos de prescripción de antimicrobianos y reportar eventos adversos relacionados con su uso. Este monitoreo contribuye a ajustar las políticas de tratamiento y a prevenir la propagación de patógenos resistentes.

El director general de la Organización Mundial de la Salud, OMS, aseguró el pasado viernes, durante la Cuarta reunión ministerial mundial sobre resistencia a los antimicrobianos, que ésta no sólo “amenaza” con hacer menos eficaces los medicamentos de los que dependen los seres humanos, sino que “ya está ocurriendo”.
Tedros Adhanom Ghebreyesus afirmó que lo que se está debatiendo no es sólo el riesgo de que la gente muera a causa de infecciones por super bacterias, sino que ya “están muriendo 1,3 millones de personas cada año”. Prosiguió afirmando que tomar medidas “es tan urgente como la acción por el clima”.
El doctor Tedros se refirió a la Declaración Política relacionada a esta materia acordada el pasado mes de septiembre por la Asamblea General de la ONU, la cual establece objetivos claros. “La tarea ahora es traducirla en acciones concretas”, indicó.